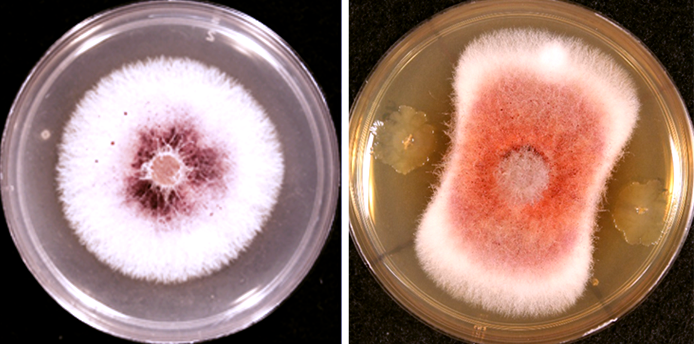

Tel: (434) 117 95 36
Red de Diversidad Biológica del Occidente Mexicano
Microbiología Ambiental Pátzcuaro
Michoacán
Red de Diversidad Biológica del Occidente Mexicano
Microbiología Ambiental Pátzcuaro
Michoacán
Líneas de investigación Formación académica Publicaciones Cursos Proyectos
Formación de recursos humanos
Líneas de investigación
Microbiología Ambiental
- Interacciones planta-suelo-microorganismos: microorganismos de la rizosfera y de la filosfera, PGPR.
- Ecología microbiana de suelos: diversidad y función de comunidades microbianas en suelos agrícolas o forestales.
- Control biológico: búsqueda de microorganismos con actividad antagónica contra hongos fitopatógenos.
Formación académica
- Postdoctorado Universidad de Griffith, Brisbane, Australia (2011-2014).
- Doctorado en Ciencias de la Tierra. UNAM, Ciudad de México (2005-2010).
- Maestría en Ciencias Ambientales. Universidad de Wageningen, Países Bajos (2002-2004).
- Escuela Nacional Superior de Agronomía y de Ciencias Alimenticias (ENSAIA), Nancy, Francia (2000-2004).
Publicaciones selectas
(últimos 5 años)
2026
- López-García CM, Rodríguez-Gómez IA, Pérez-Bautista Y, Villanueva-Espino LA, Molina Torres M, Patiño-Conde V, Ruiz-Guizar LE, García-Meléndez M, Hernández-Cristóbal O, Llanderal-Mendoza J, Quesada M, Reverchon F, Oyama K, Méndez-Bravo A. 2026. The microbiota of avocado floral nectar inhibits pathogens and improves plant fitness. Journal of Experimental Botany. https://doi.org/10.1093/jxb/erag038.
- Alfaro-García RG, Méndez-Bravo A, Reverchon F*. 2026. Modulation of the rhizosphere microbiome by soil‐borne pathogens: Digging into the pathobiome concept. Annals of Applied Biology 188: 22-33. https://doi.org/10.1111/aab.70046.
2025
- Sánchez-Hernández D*, Larsen J, Reverchon F*. 2025. Diversity of culturable endophytic fungi associated with avocado orchards under organic and conventional management. Current Microbiology 82: 466. https://doi.org/10.1007/s00284-025-04454-0.
- Gallardo-Camarena MV, Reverchon F, Méndez-Bravo A, Torres-Acosta MA, Licona-Cassani C. 2025. Control of avocado anthracnose by carposphere-associated Kosakonia cowanii VG1 for agricultural use. AMB Express 15: 88. https://doi.org/10.1186/s13568-025-01894-6.
- Omidvar N, Joseph S, Dissanayake L, Farrar MB, Reverchon F, Burnett R, Rezaei Rashti M, Amarasinghe A, Tahery S, Xu Z, Timms W. 2025. Combination of biochar‐based fertilisers and reactive barriers improved soil carbon storage, soil moisture retention, and crop yield in short term. GCB Bioenergy 17: e70021. https://doi.org/10.1111/gcbb.70021.
- Blouin M, Robin A, Amans E, Reverchon F, Barois I, Lavelle P. 2025. A meta-analysis reveals earthworms as mutualists rather than predators of soil microorganisms. Geoderma 455: 117238. https://doi.org/10.1016/j.geoderma.2025.117238.
2024
- Nieves-Campos EI, Méndez-Bravo A, Pérez-Bautista Y, Llanderal-Mendoza J, Guevara-Avendaño E, Solís-García IA, Diyarza-Sandoval NA, Contreras-Ramos SM, Rodriguez-Campos J, Méndez-Bravo A*, Reverchon F*. 2024. Anti-oomycete activity and plant growth promoting properties of avocado fungal endophytes. Rhizosphere 31; 100931. https://doi.org/10.1016/j.rhisph.2024.100931.
- Guevara-Avendaño E, Solís-García IA, Méndez-Bravo A, Pineda-García F, Angeles-Alvarez G, Madero-Vega C, Fernández-Pavía SP, Mondragón-Flores A, Reverchon F*. 2024. Bacillus sp. A8a reduces leaf wilting by Phytophthora and modifies tannin accumulation in avocado. Mexican Journal of Phytopathology 42(1): 1-16. https://doi.org/10.18781/R.MEX.FIT.2309-2.
2023
- Medina-Sauza RM, Solís-García IA, Blouin M, Villain L, Guevara R, Barois I*, Reverchon F*. 2023. Microniches harbor distinct bacterial communities at the soil-plant-earthworm interface. European Journal of Soil Biology 118: 103531.
- Reverchon F*, García-Meléndez M, Guevara-Avendaño E, Mora-Chávez O, Solís-García IA, Dáttilo W, Guerrero-Analco JA, Méndez-Bravo A, Monribot-Villanueva JL, Patiño-Conde V, Pineda-García F, Rebollar EA. 2023. Shifts in the rhizosphere microbiome and exudation profile of avocado (Persea americana Mill.) during infection by Phytophthora cinnamomi and in presence of a biocontrol bacterial strain. CABI Agriculture and Bioscience 4: 23.
- Cortazar-Murillo EM, Méndez-Bravo A, Monribot-Villanueva JL, Garay-Serrano E, Kiel-Martínez AL, Ramírez-Vázquez M, Guevara-Avendaño E, Méndez-Bravo A, Guerrero-Analco JA*, Reverchon F*. 2023. Biocontrol and plant growth promoting traits of two avocado rhizobacteria are orchestrated by the emission of diffusible and volatile compounds. Frontiers in Microbiology 14: 1152597.
- Méndez-Bravo A, Herrera-Cornelio LC, García-Toscano DF, Kiel-Martínez AL, Guevara-Avendaño E, Ramírez-Vázquez M, Pérez-Bautista Y, Méndez-Bravo A*, Reverchon F*. 2023. Beneficial effects of selected rhizospheric and endophytic bacteria, inoculated individually or in combination, on non-native host plant development. Rhizosphere 26: 100693.
- Ángeles G, Álvarez-Jiménez M, Anthelme F, Barois F, Chaparro-Carrillo JL, Cruz-Maldonado N, Decaens T, de los Santos-Bailón M, Fourtier S, García-Gutiérrez E, García-Segura D, Gómez-Aguilar R, Gómez-Anaya A, Hernández E, Hernández-Cáceres D, Jiménez L, Marín-Castro BE, Merino-Martín L., Morales-Martínez MA, Monfil-León EU, Palestina RA, Pimentel-Reyes C, Quiroz-Reyes R, Reverchon F, Rey H, Roumet C, Siebe-Grabach CD, Sieron K, Vázquez-Reyes V, Weemstra M, Stokes A. 2023. Drivers of soil biophysical processes along an elevational gradient at Pico de Orizaba volcano, Mexico. CABI Agriculture and Bioscience 4: 4. https://doi.org/10.1186/s43170-023-00146-6.
- Merino-Martín L, Hernández-Cáceres D, Reverchon F, Ángeles-Álvarez G, Zhang G, Dunoyer de Segonzac D, Dezette D, Stokes A. 2023. Habitat partitioning of soil microbial communities along an elevation gradient: from plant root to landscape scale. Oikos 2023: e09034.
2022
- Guevara-Avendaño E, Pérez-Molina ML, Monribot-Villanueva JL, Cortazar-Murillo EM, Ramírez-Vázquez M, Reverchon F*, Guerrero-Analco JA*. 2022. Identification of antifungal compounds from avocado rhizobacteria (Bacillus spp.) against Fusarium spp., by a bioassay-guided fractionation approach. Chemistry and Biodiversity 19: e202200687.
- Carrasco-Espinosa K, Avitia M, Barrón-Sandoval A, Abbruzzini TF, Salazar Cabrera UI, Arroyo-Lambaer D, Uscanga A, Campo J, Benítez M, Wegier A, Rosell JA, Reverchon F, Hernández G, Boege K, Escalante AE. 2022. Land-use change and management intensification is associated with shifts in composition of soil microbial communities and their functional diversity in coffee agroecosystem. Microorganisms 10(9): 1763. https://doi.org/10.3390/microorganisms10091763.
- Lázaro‑Castellanos JO, González D, Mata‑Rosas M, Arias S, Reverchon F. 2022. Genetic diversity and population genetic structure of three endemic species of Mammillaria (Cactaceae) from the Tehuacán Valley in central México. Biodiversity and Conservation 31: 1057-1072. https://doi.org/10.1007/s10531-022-02378-w.
- Medina-Sauza RM, Álvarez-Jiménez M, Ortíz-Huerta Y, Ruiz-Sayago E, Blouin M, Villain L, Guevara R, Sangabriel W, Reverchon F*, Barois I*. 2022. Bulk and rhizosphere soil properties under two Coffea species influenced by the earthworm Pontoscolex corethrurus. Rhizosphere 21: 100458.
- Hernández-Cáceres D, Stokes A, Angeles-Alvarez G, Abadie J, Anthelme F, Bounous M, Freschet GT, Roumet C, Weemstra M, Merino-Martín L, Reverchon F. 2022. Vegetation creates microenvironments that influence soil microbial activity and functional diversity along an elevation gradient. Soil Biology and Biochemistry 165: 108485.
- Romero-Uribe HM, López-Portillo J, Reverchon F, Hernández ME. 2022. Effect of degradation of a black mangrove forest on seasonal greenhouse gas emissions. Environmental Science and Pollution Research 29: 11951-11965. https://doi.org/10.1007/s11356-021-16597-1.
Actividades de difusión
- “Patobioma: aliados o enemigos del patógeno”. 2025. Alfaro-García R, Reverchon F, Méndez-Bravo A. En: La Crónica. https://www.cronica.com.mx/academia/2025/03/25/patobioma-aliados-o-enemigos-del-patogeno/
- “Los ayudantes microscópicos del árbol de copal”. 2024. Castro-Azuara RM, López-García CM, Rico Y, Reverchon F. En: Eco-Lógico 5(2): 44-49.
- “Superhéroes ocultos en las plantas”. 2024. Rodríguez Mina YG, Reverchon F, Guerrero Analco JA. En: La Crónica. https://www.cronica.com.mx/academia/superheroes-ocultos-plantas.html
- “Salvias silvestres y sus microbios asociados”. 2023. Reverchon F, Bedolla García BY, Gargallo Gaona JA. En: Eco-Lógico 4(4): 18-23.
- “We need more female mentors”. 2023. Reverchon F. En: The Source, Springer. https://www.springernature.com/gp/researchers/the-source/blog/blogposts-communicating-research/we-need-more-female-mentors/24004096
- “Acercándonos a lo invisible”. 2023. Reverchon F. En: La Crónica. https://www.inecol.mx/inecol/index.php/es/ct-menu-item-25/ct-menu-item-27/17-ciencia-hoy/1921-acercandonos-a-lo-invisible
- “Los hongos inquilinos de las plantas”. 2022. Reverchon F. Nieves-Campos EI, Méndez-Bravo A. En: Eco-Lógico 3(4): 28-35.
Trabajo editorial
- 2024 – presente: Editora Asociada de la revista Journal of Soils and Sediments (Springer Nature).
- 2023 – presente: Miembro del Comité Editorial de la revista Rhizosphere (Elsevier).
- 2022 – presente: Editora para la revista Microbiology Spectrum (American Society of Microbiology).
- 2021 – presente: Editora Asociada para la revista CABI Agriculture & Bioscience (CABI A&B), área “Forestry”.
Cursos impartidos
Coordinadora y profesora del curso Microbiología Ambiental (60 h). Curso de Posgrado del INECOL.
Profesor invitado de cursos de Posgrado del INECOL:
- Estudios Moleculares de Sistemas Biológicos
- La biodiversidad en el suelo, importancia y aplicaciones
- La carrera científica
Proyectos de investigación actuales

Descifrando las interacciones microbianas en leguminosas nativas mexicanas

Efecto de fitopatógenos sobre la estructura y la función de las comunidades microbianas rizosféricas

Búsqueda de agentes microbianos de biocontrol para mitigar el impacto de hongos patógenos

Efecto del cambio de uso del suelo en la franja aguacatera michoacana sobre las comunidades microbianas del suelo


Microbiomas de cultivos y sus parientes silvestres: el caso de la chía
Formación de recursos humanos
(últimos 5 años)
Doctorado
- Regina María Medina Sauza, INECOL. 2023. “Earthworm's abiotic and biotic influence at the root-soil interface of two Coffea species”. Co-dirección con la Dra. Isabelle Barois (INECOL).
Maestría
- Gabriela Rodríguez Mina, INECOL. 2025. “Evaluación del potencial promotor de crecimiento vegetal del hongo endófito Metapochonia sp. en jitomate (Solanum lycopersicum L.) bajo condiciones in vitro y de invernadero”. Co-dirección con el Dr. José A. Guerrero Analco (INECOL).
- Nayeli Angélica Diyarza Sandoval, INECOL. 2025. “Actividad antifúngica y promotora de crecimiento vegetal de bacterias filosféricas de árboles de aguacate”.
- Mariel García Mélendez, INECOL. 2023. “Efecto de la infección por Phytophthora cinnamomi sobre la diversidad y estructura de la comunidad microbiana asociada a la rizosfera del aguacate (Persea americana Mill.)”. Co-dirección con la Dra. Eria Rebollar Caudillo (CCG, UNAM).
- Itzel Anayansi Solís García, INECOL. 2022. “Cambios en la microbiota activa de la rizósfera del aguacate ocasionados por Fusarium kuroshium”. Co-dirección con el Dr. Alfonso Méndez Bravo (SECIHTI-UNAM).
Licenciatura
- Nayeli Angélica Diyarza Sandoval, INECOL - Benemérita Universidad Autónoma de Puebla. 2022. “Agentes de control biológico contra hongos fitopatógenos del género Fusarium: estado del arte y búsqueda de bacterias promisorias”.
- Indira Aranza Rodríguez Gómez, Universidad Michoacana San Nicolás de Hidalgo. 2022. “Actividad antagónica de microorganismos cultivables del néctar floral del aguacate Persea americana”. Co-dirección con el Dr. Alfonso Méndez Bravo (SECIHTI-UNAM).


